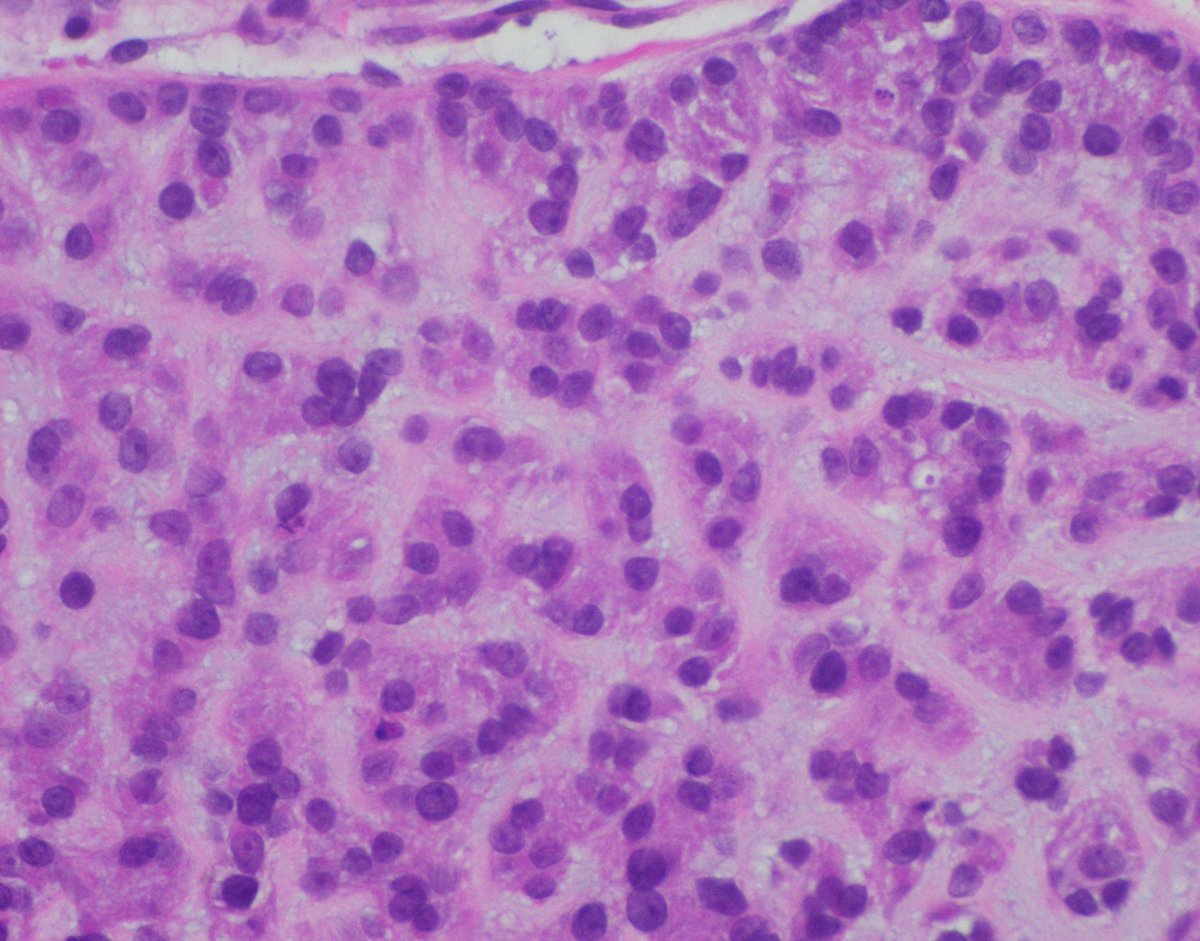
MonicaGarciaBuitrago tweet media

Melissa D. retweetledi

Our GI Pathology Fellowship has an unexpected opening for July 2026. Dr. Ortiz (right) and I are the program directors. We have superb cases and excellent colleagues (Drs. M. Garcia, R. Yantiss, S. Al Diffalha, O. McDonald). Send your CV to adriana.zanaty@miami.edu

English